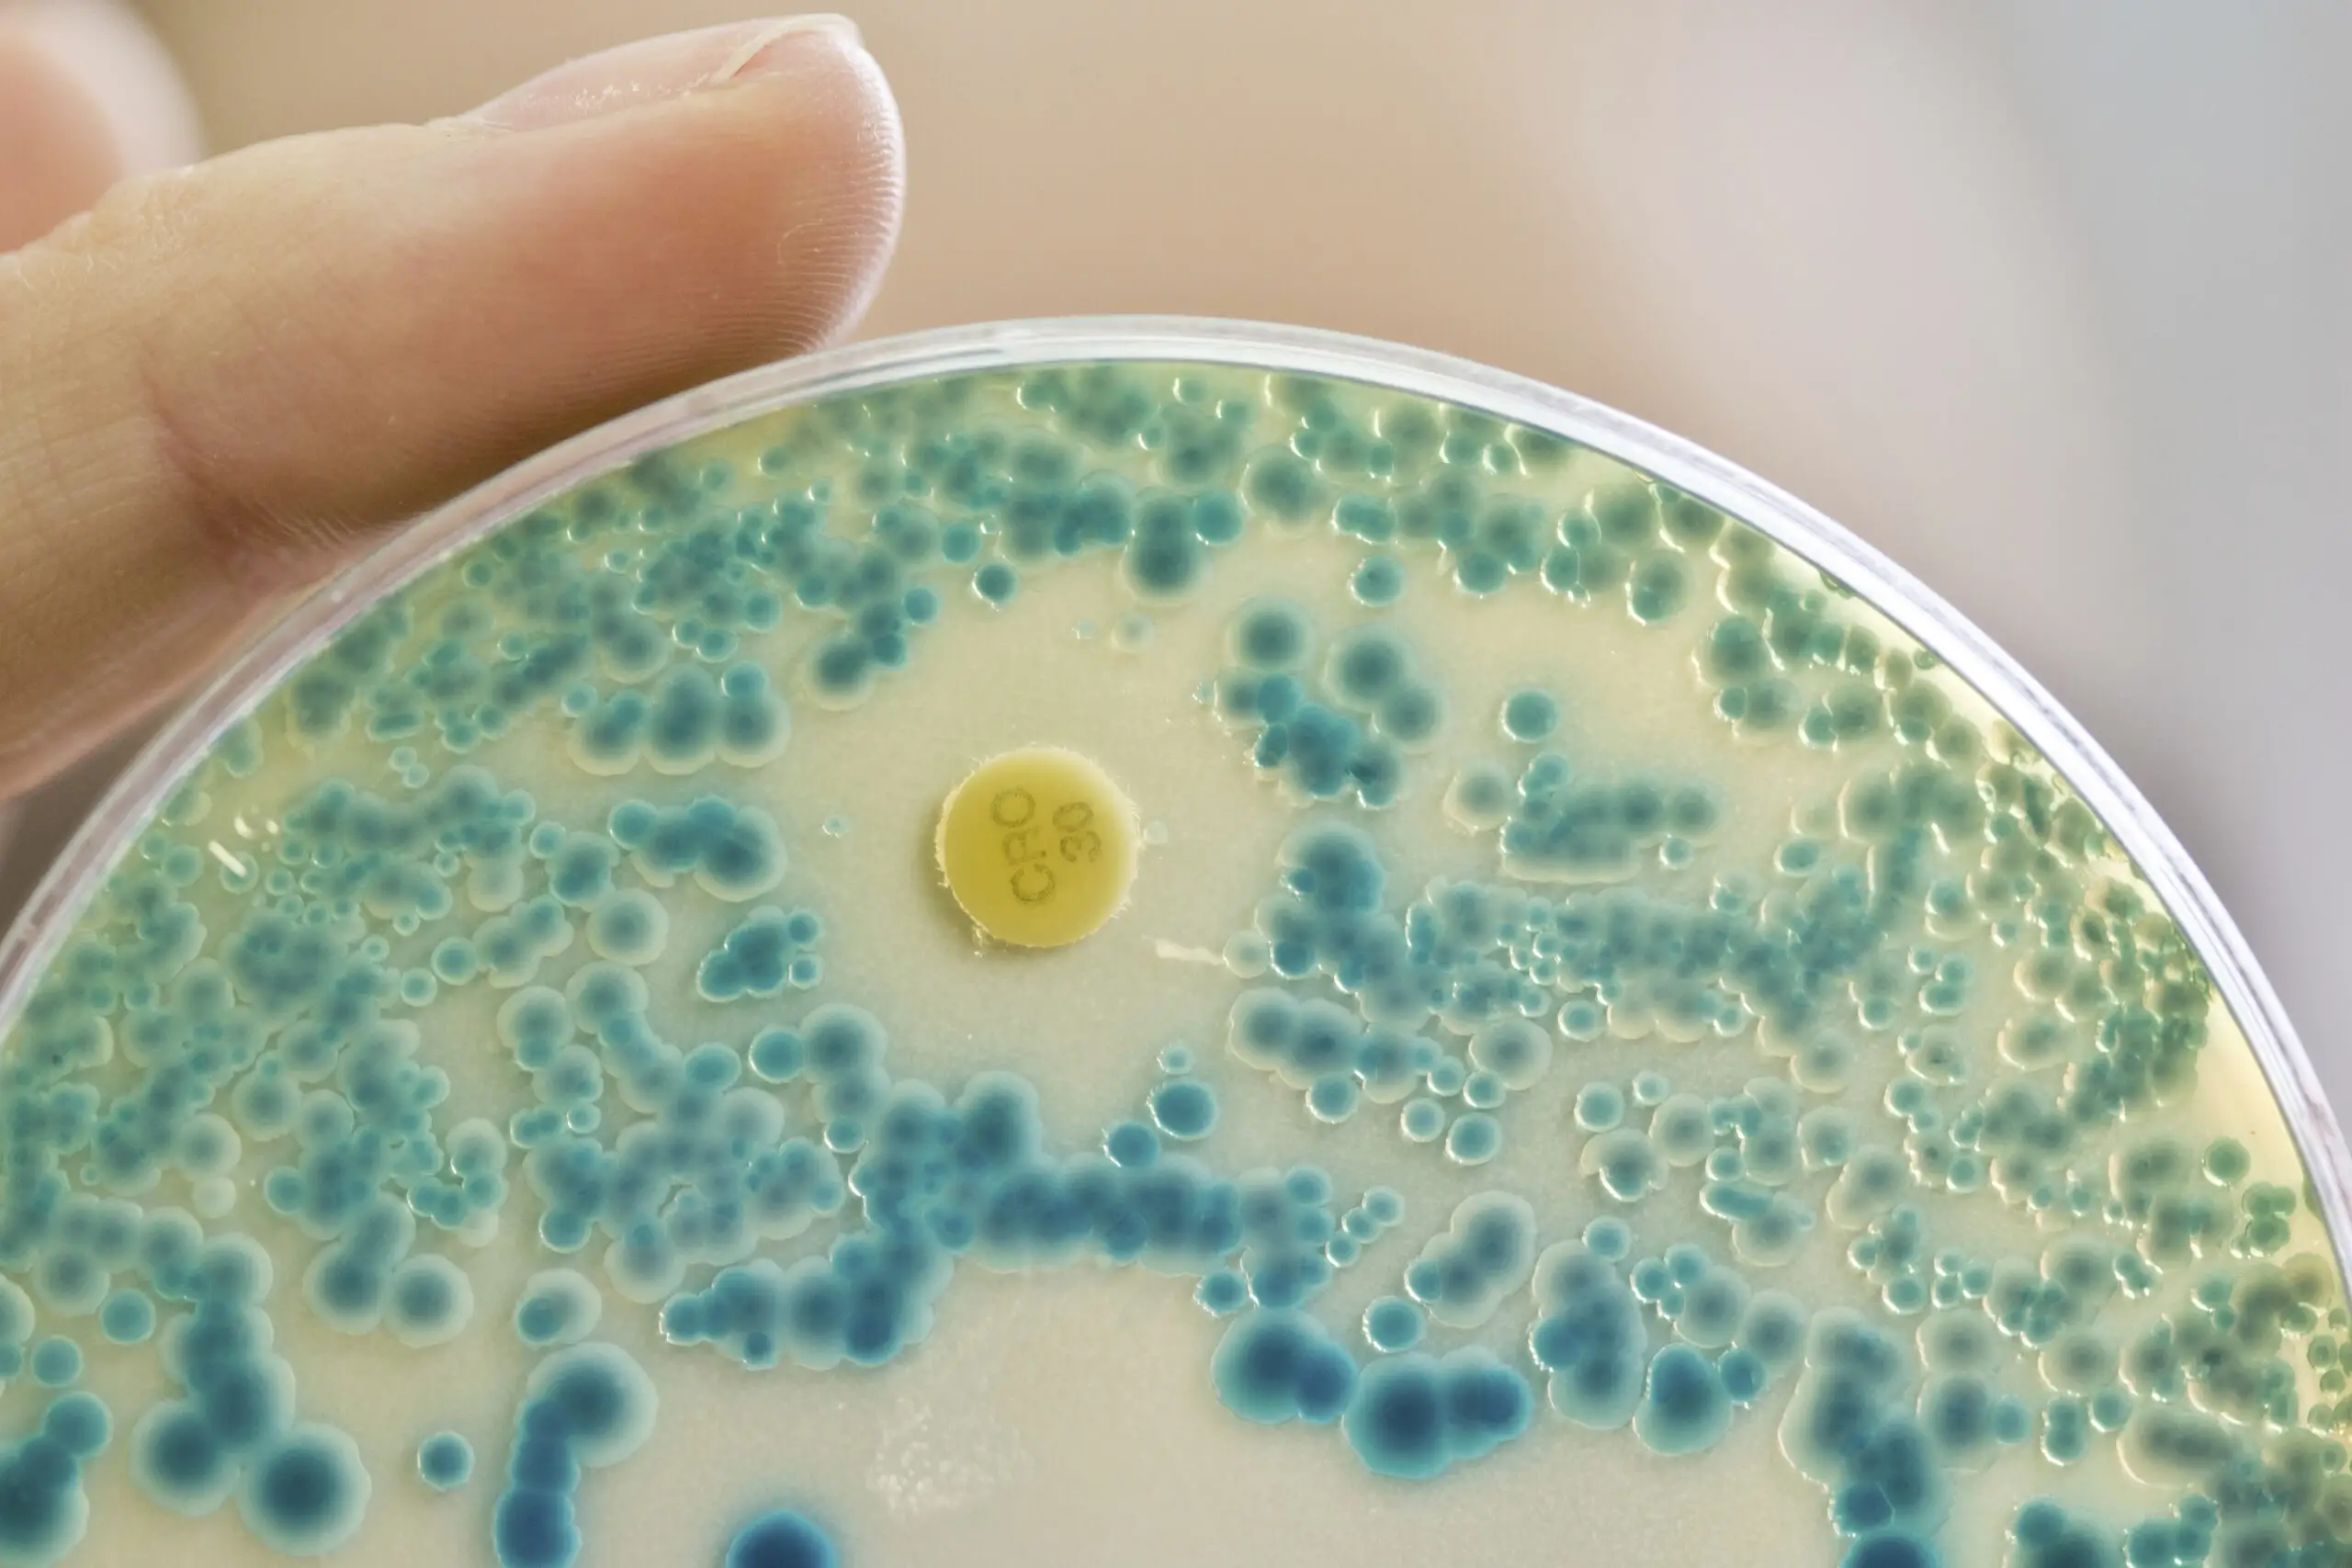

s
Tutte le prime pagine di oggi su Giornalone.it
Salute
Che cos’è la meningite tubercolare che ha colpito la bimba ricoverata a Bologna
Oggi 04-02-26, 16:05
Meningite tubercolare: colpita una bimba di due anni e mezzo ricoverata al Sant’Orsola di Bologna. Questo articolo Che cos’è la meningite tubercolare che ha colpito la bimba ricoverata a Bologna proviene da LaPresse
CONTINUA A LEGGERE

6

0

0








